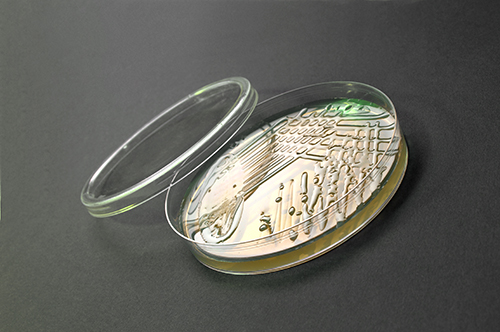
QI-v-Contipru

Farmaceutický priemysel patrí medzi jedno z najrýchlejšie sa vyvíjajúcich odvetví. Tejto eskalácii sa musia zákonite prispôsobiť aj ERP systémy, ktoré ponúkajú riešenie pre avizovaný odbor. Naviac by malo ísť o praxou overené softvéry, pretože sankcie za nedodržanie podmienok výroby a následná zodpovednosť sú tu veľmi vysoké. Aké sú najčastejšie požiadavky na informačné systémy pre farmaceutický priemysel a ako im tieto moderné technológie dokážu ísť naproti? Nielen to sa dočítate v nasledujúcej prípadovej štúdii.
Spoločnosť Contipro ako výrobca kyseliny hyaluronovej pôsobí na trhu už od roku 1990. Špičková kvalita produktov dostala podnik na svetovú úroveň, čo je dané aj tým, že kladie veľký dôraz na inovácie a vlastný výskum. Momentálne ovláda 60 % európskeho a 30 % svetového trhu s hyaluronanom ako surovinou pro farmaceutický a kozmetický priemysel. Kyselina hyaluronová nie je len módnou záležitosťou, ale aj vysoko účinnou látkou, ktorá pomáha okrem iného pri rekonštrukcii poškodených tkanív.
Dáta pod strechou za tri mesiace
Rovnako ako sa postupne rozvíjala spoločnosť a jej technologické zázemie, zväčšovala sa aj potreba zaštítiť firemné procesy komplexným informačným systémom. Pôvodné riešenie, ktoré využívalo DOS platformu, spoločnosti prestalo stačiť, preto vypísala výberové konanie. Prihlásilo sa do neho päť dodávateľov softvéru, QI zvíťazilo. „Od nového informačného systému sme v prvom rade požadovali, aby bol vhodný pre našu prácu. QI s jeho škálou modulov umožňuje firmám našej veľkosti zvoliť vhodné nástroje. Ďalej sme vyžadovali, aby systém zodpovedal legislatíve, bol jednoduchý na obsluhu a aby dáta v ňom dali jednoducho nájsť. To všetko sme v QI našli,“ za Contipro povedal správca informačných systémov Michal Moravec.

Implementácia QI, ktorú zabezpečovala spoločnosť IT link, začala v októbri roku 2002. Behom prvého mesiaca sa nainštalovala prevádzková databáza a naplnili sa základné číselníky. Na prelomu roku sa potom previedli dáta z výroby, v januári už Contipro bežalo v ostrej prevádzke. Teraz s QI pracuje až 50 užívateľov denne.
Objednávky pod kontrolou
Pretože sa Contipro zameriava aj na individuálne zákazky, požadovalo, aby túto formu reflektoval informačný systém. „S naším implementačným partnerom sme upravili a nastavili obchodné moduly QI tak, aby vyhovovali všetkým našim požiadavkám a zjednodušili nám evidenciu jednotlivých zákaziek,“ vysvetlil Moravec. Vďaka presným a prehľadným záznamom o každom obchodnom prípade sa Contipro môže stopercentne sústrediť na svojich zákazníkov a udržiavať s nimi pevný vzťah. „Naviac sme sprevádzkovali sledovanie efektivity výskumných a vývojových prác a tak môžeme lepšie vychádzať v ústrety aj tým zákazníkom, ktorí sami nedisponujú dostatočným vývojovým zázemím,“ dodal Moravec.
Záujem renomovaných farmaceutických firiem z celého sveta o kyselinu hyaluronovú z Contipra neustále stúpa, preto rastie počet zákaziek, ktoré je potrebné spracovať. Vo firme je teda nevyhnutná dôkladná a presná evidencia ich stavu. „Každý zamestnanec si môže QI nastaviť tak, aby sa mu s ním dobre pracovalo. Práca s ním je jednoduchá, nie je potrebná žiadna softvérová odbornosť. Veľmi oceňujeme aj skutočnosť, že dáta sú jednoducho prenositeľné z QI do iných aplikácií,“ povedal Moravec. Contipro totiž okrem iného využíva úzko špecializované laboratórne systémy.
S QI k optimalizácii nákladov
Na podniky z farmaceutického a kozmetického priemyslu sa kladú veľké legislatívne aj kvalitatívne nároky. Preto je nutné priebežne upravovať procesy a zároveň zabezpečiť aby sa dali ľahko a rýchlo nájsť všetky kľúčové informácie, ktoré či už priamo, alebo nepriamo ovplyvňujú kvalitu a bezpečnosť produktov. Aj v tejto oblasti QI uľahčuje prácu. Spoločnosť využíva výstupy zo systému napríklad pri spracovaní auditov a certifikácií. „Vďaka širokým možnostiam QI sa nám tiež podarilo dosiahnuť optimalizáciu nákladov na výrobu a administratívu,“ oznámil Moravec.